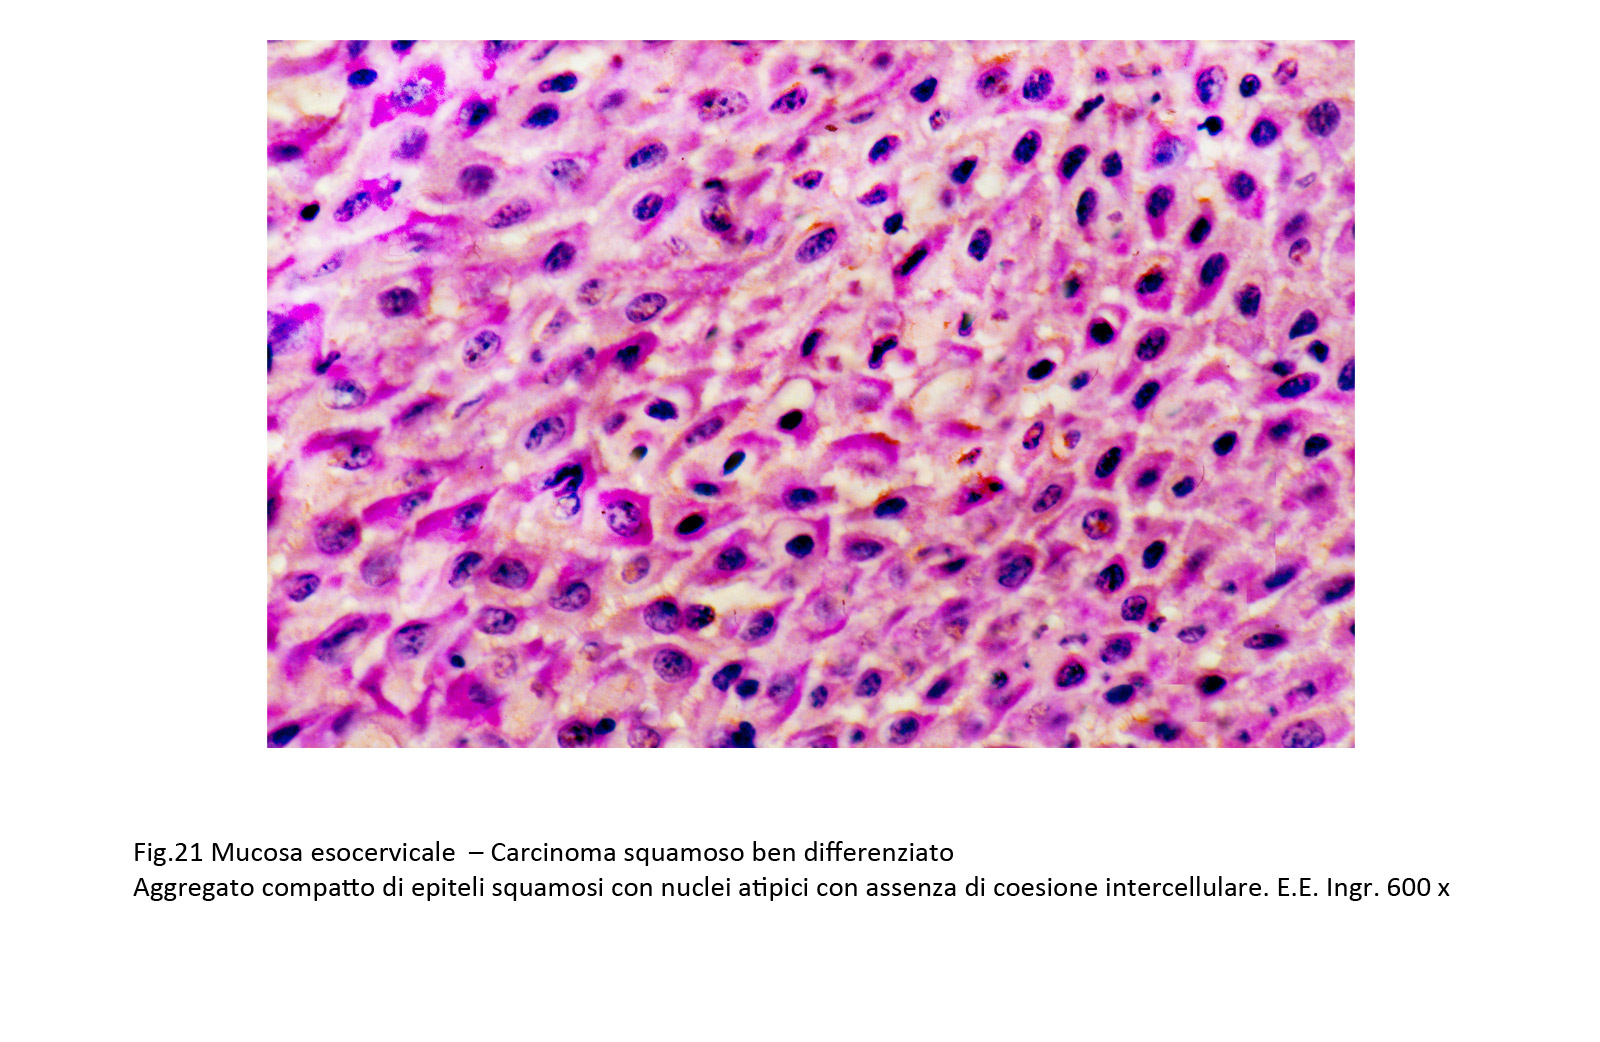
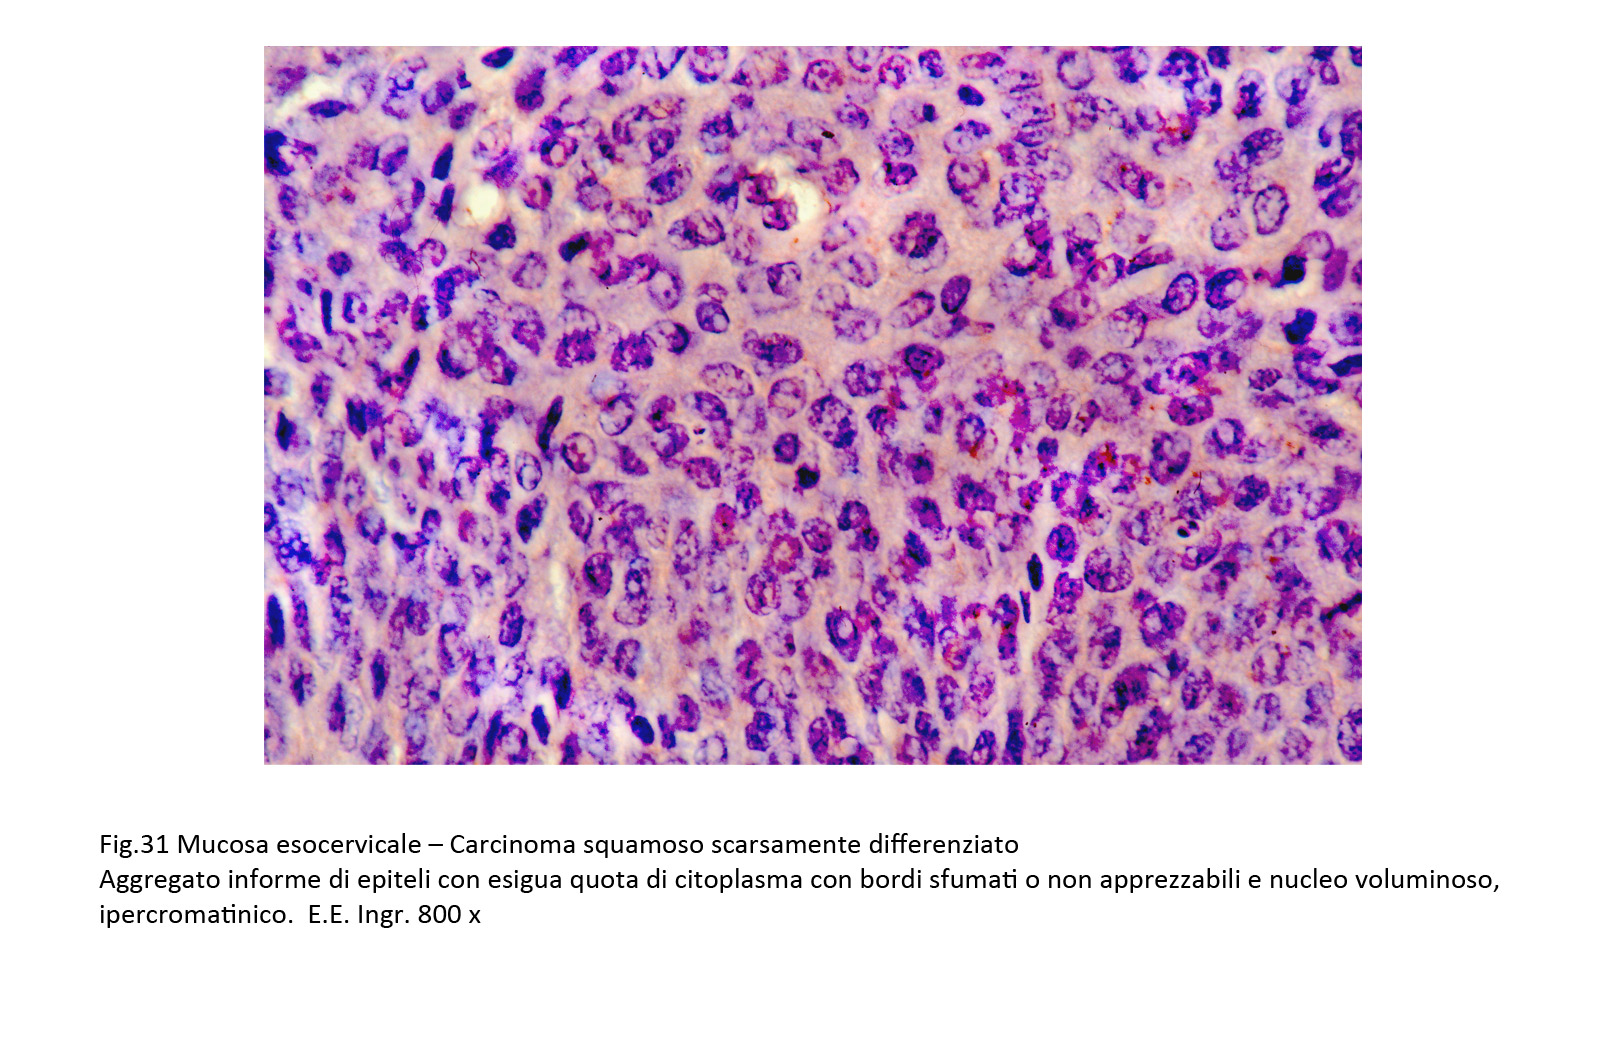

Cervice uterina:
dalle lesioni intraepiteliali al carcinoma squamoso
Prof. Luigi Cuccurullo
Emerito di Anatomia Patologica dell'Università della Campania "Luigi Vanvitelli"
L’esame istopatologico dell’esocervice richiede l’osservazione dello stato della linea epiteliale di rivestimento ed assieme ad esso la valutazione dell’assetto vasculostromale di supporto.
La lettura al microscopio della mucosa esocervicale richiede l’esame di alcune componenti quali l’architettura del rivestimento epiteliale con eventuali fenomeni di metaplasia e di proliferazione, la presenza di focolai flogistici, le modificazioni dello stroma con neoangiogenesi e non in ultimo le alterazioni intraepiteliali da HPV.
Un paragrafo importante di questo capitolo della patologia è rappresentato proprio dalle alterazioni intraepiteliali da HPV; esso è un processo proliferativo progressivo, ingravescente, evolvente a tappe verso il carcinoma in situ e successivamente verso il carcinoma invasivo (J. Clin. Pathol. 1982; 35: 1-13) (Adv. Anat. Pathol. 2021; 28(3): 150-170).
A questa diagnosi istopatologica si perviene dopo aver escluse le alterazioni epiteliali dovute a metaplasia matura o immatura, la semplice iperplasia degli epiteli basali e parabasali, le alterazioni epiteliali su base reattiva, i fenomeni destrutturanti indotti da processi flogistici, le atipie epiteliali in corso di riparazione della mucosa, in casi di atrofia degli epiteli per perdita dei gradi di maturità (Brit. Med. J. 1989; 298: 707-710).
Queste lesioni da HPV rientrano nel capitolo delle SILS (Squamous Intraepithelial Lesions) della cervice uterina consistenti in una proliferazione degli epiteli squamosi con anormalità maturativa, e con alterazioni citologiche,proliferazione che rimane raccolta nei limiti della membrana basale.
Attualmente, queste lesioni proliferative intraepiteliali da HPV sono inquadrate secondo il criterio LAST (Lower Anogenital Squamous Terminology) che utilizza la stessa terminologia per le lesioni squamose associate alla presenza di questo virus nel tratto ano-genitale (M.R. Nucci, C. Pazza-Herran – Gynecologic Pathology, Elsevier, 2022).
Secondo il criterio LAST, le lesioni intraepiteliali squamose sono differenziabili in due tipi indicati con le sigle LSIL (Low-grade Cervical Squamous Intraepithelial Lesions) e HSIL (High-grade Cervical Squamous Intraepithelial Lesions) distinguibili su la base di criteri strutturali e citologici (Sci Rep. 2022; 12: 7613).
Le lesioni indicate con la sigla LSIL sono armonizzate con quelle che in precedenza erano indicate con la sigla CIN 1 (Cervical Intraepithelial Neoplasia1).
In queste lesioni, il rivestimento epiteliale appare ispessito acquisendo a seconda dei casi una configurazione piana, papillomatosa o condilomatosa. A livello citologico, si evidenzia una attività proliferativa degli epiteli basali e parabasali e presenza negli strati superficiali di epiteli ipercheratosici, paracheratosici e koilocitosici. La maturazione degli epiteli in senso squamoso viene conservata, ma i nuclei appaiono ingranditi, ipercromatinici, irregolari, con possibile presenza di elementi binucleati, o plurinucleati.
Questa lesione è considerata a lieve rischio, è auto-limitante e non è tendente ad uno sviluppo carcinomatoso. Risulta confermato l’assunto secondo il quale la forma di LSIL in una esigua percentuale di casi possa evolvere in quella di HSIL, mentre nella maggior parte dei casi tende spontaneamente ad autoeliminarsi (Diagnostics Basel, 2020; 10(8): 595).
La lesione indicata con la sigla HSIL, si manifesta secondo due livelli di gravità; questi sono armonizzati con i reperti in passato indicati con le sigle CIN 2 e CIN 3 e si appalesano a livello istopatologico con i seguenti caratteri:
HSIL- CIN 2:
Gli strati epiteliali sono costituiti fino ai due terzi superiori da epiteli simili a elementi basali e parabasali, spesso in mitosi; i loro nuclei sono irregolari, voluminosi, ipercromatinici, e la loro volumetria è causa di una inversione del rapporto nucleo- citoplasma.
HSIL- CIN 3:
Gli strati epiteliali sono costituiti solo da cellule basali e parabasali con scarsa maturazione; queste sono fornite di nuclei voluminosi, dal profilo irregolare contenente cromatina a blocchi.
La disposizione spaziale di questi elementi è priva di qualsiasi ordine o disegno ed è punteggiata da numerose mitosi tipiche ed atipiche Questo reperto viene considerato, nella sua massima espressività morfologica quale carcinoma in situ.
Accanto a questa, che viene considerata la forma classica dell’HSIL-CIN 3, esistono alcune varianti, qui di seguito riportate (WHO, Female Genital Tumours, 5th Ed., 2020):
1) VARIANTE THIN:
Il reperto si manifesta con un esiguo numero di strati epiteliali ( nove strati o meno) e può essere confuso con un quadro di atrofia del rivestimento epiteliale. Tale variante può manifestarsi come tale dall’inizio oppure derivare da una pregressa forma classica; essa è stata rilevata con maggiore frequenza a livello delle aree di giunzione-squamo-colonnari. (Histopathology 2019; 75(3): 405-412).
2) VARIANTE PLEOMORFA:
E’ stato rilevato, a livello di aree circoscritte o con modalità diffuse, la esistenza di quadri di HSIL caratterizzati da elementi con nuclei pleomorfi, voluminosi ipercromatinici, con nucleoli prominenti e sedi di un numero cospicuo di mitosi tipiche ed atipiche. Il diametro di ciascuno di questi nuclei può raggiungere le dimensioni di circa 4 volte quello degli elementi basali. I singoli epiteli possono essere sedi di un doppio nucleo o addirittura essere plurinucleati. Si accrescono coinvolgendo la mucosa endocervicale e le sue ghiandole.
Questa variante non è considerata più aggressiva rispetto alla forma classica di HSIL; essa viene considerata simile a quadri di displasie bizzarre, con nuclei giganti,con anisonucleosi, con ipercromasia,e con plurinuclei (J. Gynecol. Res. 2017; 43: 345-351) (Pathology 2018; 50: 369-370) (Diagnostics (Basel) 2020;10(8): 595).
3) VARIANTI CHERATINIZZANTI,E PAPILLARI
Nell’ambito di questo capitolo di patologia proliferativa degli epiteli è possibile il repertare quadri istopatologici caratterizzati dalla presenza di quote cospicue di epiteli cheratinizzati oppure di escrescenze papillari monoassili o variamente ramificate. Queste forme si differenziano dalle omologhe lesioni iperplastiche per essere costituite da epiteli atipici e per la esistenza di una disposizione spaziale disordinata.
Per la diagnostica dei processi proliferativi intraepiteliali dell’esocervice i reperti morfologici sono determinanti; tuttavia in molti quadri di incertezza interpretativa è indispensabile ricorrere ad indagini di immunoistochimica. I marcatori maggiormente utilizzati in questa forma di patologia sono le citocheratine7, il Ki67 e la p16 ( Mod. Pathol. 2010; 23(8): 1045-1051).
Si fa ricorso alla marcatura con la citocheratina7 per svelare il grado di maturazione in senso squamoso di gruppi di epiteli o di strati epiteliali a livello dei quali il processo maturativo è di difficile valutazione. Si avvale della marcatura del Ki67 allorquando è necessario stabilire i livelli di proliferazione degli epiteli in esame; ciò può porsi per differenziare le forme di LSIL in fasi iniziali da reperti di mucosa normale o ancora per distinguere le forme proliferative, di natura neoplastiche da reperti non neoplastici quali le iperplasie indotte da flogosi e le metaplasie immature (Int. J. Gynecol. Pathol. 2006; 25: 101-120) (J. Lab. Phys. 2017; 9(2): 104-110).
Si ricorre alla marcatura con la p16, in diverse condizioni di patologia e soprattutto per poter differenziare le forme di LSIL da quelle di HSIL (CIW2) (Am. J. Surg. Pathol. 2015; 39(12): 1708-1718) (Sci Rep. 2022; 12: 7613).
In tutti i processi proliferativi epiteliali, dalle semplici iperplasie alle displasie, ai carcinomi in situ o invasivi, si riscontra un rimaneggiamento delle strutture vasculo-stromali con la preminenza della neoangiogenesi (Mol. Cell. 2014; 54: 559-572).
Tale processo si riscontra anche nei casi di proliferazione intraepiteliale dell’esocervice e la entità della neoangiogenesi e in certi limiti è proporzionata alla gravità del processo proliferativo; pertanto essa è di grado inferiore nelle forme di LSIL rispetto a quanto si riscontra nei processi di HSIL (Virology 2007; 367(2): 168-174).
I capillari neoformati sono forniti solo di endoteli, i vasi maggiormente strutturali sono avvolti da periciti e da elementi mesenchimali. Le pareti sono sottili, fragili e frequentemente possono essere infiltrate da elementi della flogosi e da elementi mesenchimali circostanti (Adv. Biomed. Res. 2023; 12: 124).
Il processo di neoangiogenesi è multifattoriale ma è indotto in modo precipuo dal VEGF, secreto dagli epiteli atipici in attività proliferativa; prodotto da alta azione mitogena su le cellule endoteliali, mediatore della permeabilità e presente ad alta concentrazione nei tumori (British J. Cancer 1997; 76 (11): 1410-1415).
REPERTI
Il rivestimento epiteliale dell’esocervice è ispessito per un aumento degli strati cellulari. La disposizione spaziale di questi elementi è conservata sebbene siano presenti fenomeni proliferativi con focolai di addensamento cellulare.
Fig.1 
In particolare, sono maggiormente ispessiti gli strati epiteliali basali e parabasali con presenza nel loro ambito di elementi in mitosi atipici. Gli strati intermedi e superficiali del rivestimento sono costituiti di epiteli squamosi con buon livello di maturazione del citoplasma; questi elementi contengono un nucleo voluminoso, irregolare, ipercromatinico, spesso picnotico, demarcato da un alone iperchiaro del citoplasma.
Fig.2  Fig.2part
Fig.2part 
Fig.3  Fig.4
Fig.4 
Fig.4part  Fig.5
Fig.5 
A questo processo proliferativo si associa, spesso, la presenza di vasi neoformati nel contesto degli strati epiteliali a partenza dalla tonaca propria. Abitualmente sono capillari rivestiti solo da elementi endoteliali i quali sono avvolti dagli epiteli in proliferazione; non mancano reperti in cui coesistono nella stessa area vasi con ampio lume e capillari forniti non solo da elementi ma anche da periciti.
Fig.6  Fig.6part
Fig.6part 
Lo stroma sotto-epiteliale appare coinvolto da processi di flogosi e da manifestazioni di neoangiogenesi: La flogosi è sostenuta da elementi mononucleati che si addensano attorno ai capillari e si ritrovano anche tra gli strati epiteliali. I vasi sono rappresentati da capillari spesso avvolti da elementi flogistici o da fibroblasti neoformati. Essi nel loro proliferare si ritrovano anche in sede intraepiteliale, spesso pervenendo agli strati superficiali.
Fig.7  Fig.7part
Fig.7part 
I reperti riguardanti le forme proliferative intraepiteliali di alto grado sono distinti, secondo i criteri riportati in letteratura nei seguenti due gruppi: HSIL -CIN 2 e HSIL-CIN 3
Il processo proliferativo è presente a livello di tutti gli strati epiteliali; esso interessa in modo più accentuato gli strati basali e parabasali e si estende meno intenso agli strati superficiali presentando un processo maturativo squamoso incompleto e parziale. I nuclei, in tutti gli strati, appaiono voluminosi, ipercromatinici, hanno forma irregolare e frequentemente si riscontrano mitosi tipiche e atipiche. La coesione intercellulare è ridotta o è assente. La componente citoplasmatica è ridotta, mostra margini sfumati ed è sede di vacuoli o in preda a lisi.
Fig.8  Fig.9
Fig.9 
Fig.10  Fig.11
Fig.11 
Il processo proliferativo degli epiteli dell’esocervice è molto accentuato e non si associa a fenomeni di maturazione squamosa. Gli strati epiteliali, nelle forme classiche, sono molto numerosi, sono privi di una ordinata organizzazione spaziale e mostrano un costante monomorfismo dalle zone basali a quelle superficiali. La coesione intercellulare è esigua od assente, la componente citoplasmatica è ridotta ad un sottile orletto, invece quella nucleare è data da masse nucleari voluminose, ipercromatiniche, irregolari, con cromatina addensata e con nucleoli prominenti. Non mancano frequenti mitosi tipiche ed atipiche.
Fig.12  Fig.13
Fig.13  Fig.14
Fig.14 
Nei casi di HSIL-CIN 2 e in quelli HSIL-CIN 3 si riscontra a livello dello stroma sottoepiteliale un rimaneggiamento indotto dalla neoformazione di vasi, da una proliferazione di fibroblasti e da infiltrati flogistici sostenuti da mononucleati. Questa neoangiogenesi, formata soprattutto da capillari si proietta tra gli strati epiteliali sovrastanti, dissociandoli e favorendo una copartecipazione di elementi flogistici.
Fig.15  Fig.16
Fig.16  Fig.17
Fig.17 
Fig.18  Fig.19
Fig.19 
I carcinomi squamosi della cervice sono simili a quelli riscontrati a livello di altri organi. Hanno un profilo citologico lamellare, piatto, sono forniti di un ampio citoplasma eosinofilo con nucleo con i caratteri dell’atipia posizionato al centro del corpo cellulare. Essi vengono distinti, in base al loro livello di differenziazione, in tre gradi; ben differenziati, moderatamente differenziati, scarsamente differenziati.
- 1. Carcinoma squamoso ben differenziato
La neoformazione è costituita da una popolazione epiteliale iperdensa; questa è formata da epiteli squamosi disposti astrati piani ma privi di coesione intercellulari; i singoli elementi hanno ampio citoplasma acidofilo e contengono al centro un voluminoso nucleo ipercromatinico.
Fig.20  Fig.21
Fig.21
La variante con abbozzi di perle cornee non cheratinizzate è costituita da elementi pleomorfi che si dispongono a fasci o in modo solido e tendenti a formare strutture a strati concentrici; molto spesso questi aggregati sferoidali sono occupati da epiteli squamosi in corso di cheratinizzazione.
Fig.22  Fig.23
Fig.23  Fig.24
Fig.24 
Il carcinoma squamoso nella variante moderatamente differenziata è costituito da epiteli squamosi privi di coesione intercellulare e con differenti gradi di maturazione fino alla presenza di elementi scarsamente differenziati. Questi epiteli sono forniti di quote variabili di citoplasma, e sono centrati da nuclei atipici, dal profilo irregolare. Spesso sono sedi di s di vacuolizzazione o di focolai di necrobiosi.
Fig.25  Fig.26
Fig.26  Fig.27
Fig.27 
Il carcinoma squamoso scarsamente differenziato è formato di epiteli privi di maturazione squamosa. Questi elementi sono monomorfi, sono scarsamente differenziati o indifferenziati e sono organizzati in ammassi informi; hanno un esiguo citoplasma con un orletto poco apprezzabi, mentre i nuclei sono voluminosi, irregolari, ipercromatinici, spesso in mitosi. In tale contesto morfologico è possibile reperire epiteli voluminosi, a margini indistinti, contenenti due voluminosi, ipercromatinici nuclei (epiteli binucleati).
Fig.28  Fig.29
Fig.29  Fig.30
Fig.30 
Fig.31 Fig.32
Fig.32 
COMMENTO
Le lesioni proliferative squamose intraepiteliali della cervice sono processi pre-neoplastici con evoluzione verso il carcinoma squamoso invasivo.
Queste lesioni sono considerate come un’unico processo proliferativo con passaggi attraverso fasi di transizione.
La identificazione morfologica di questo tipo di patologia richiede la esclusione di reperti di tipo non neoplastico quali i processi proliferativi su base reattiva, le manifestazioni di metaplasia squamosa immatura, le iperplasie con atipie nucleari, i processi flogistici cronici con alterazioni nucleari.
Superata questa valutazione discriminante, la lettura di questi reperti poggia su tre parametri quali il processo proliferativo degli epiteli, il grado di maturazione in senso squamoso degli stessi e non ultimo le irregolarità dei nuclei indotte dall’infezione da HPV di basso o di alto rischio.
Questi parametri vengono applicati inizialmente secondo modalità di tipo qualitativo per pervenire alla identificazione delle lesioni, successivamente in modo semi-quantitativo per poter differenziare la gradualità del danno secondo lo schema tripartito di LSIL, di HSIL (CIN2) e di HSIL (CIN3).
Gli stessi criteri sono applicati per differenziare queste forme dal carcinoma squamoso inizialmente invasivo attraverso fasi di passaggio da reperti di HSIL a quelli di carcinoma squamoso. Non solo si appalesano aspetti transizionali tra queste due patologie, ma si ritrovano coesistenti focolai identificabili come HSIL accanto a focolai di carcinoma squamoso in situ o microinvasivo.
Problemi di diagnosi differenziale si pongono nella valutazione delle varianti di HSIL. Tra queste varianti sono di particolare interesse la forma di HSIL a strati epiteliali sottili e la forma di HSIL a epiteli pleomorfi.
Nella prima forma è necessario stabilire se essa si appalesi come tale ex novo oppure sia una forma classica con desquamazione degli epiteli.
Nella seconda forma è indispensabile verificare se le tipologie pleomorfe degli epiteli siano di tipo degenerativo-regressivo oppure varianti biologicamente attive e progressive.
E’ opportuna anche un’analisi dello stroma sottoepiteliale e in particolare della componente vascolare. In particolare l’attenzione deve essere rivolta alla neoangiogenesi in considerazione che questo reperto può rappresentare il substrato anatomico per la dispersione di epiteli atipici in senso metastatico.
